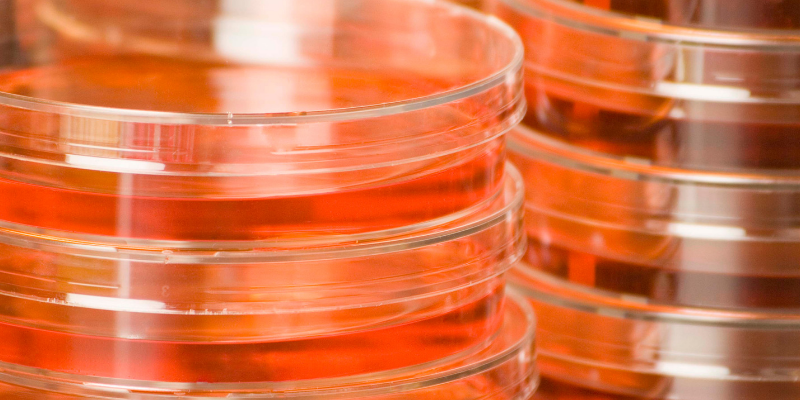
Untitled design (3)

Even more mysterious than what we should call cell-based meat is how it is produced. Cell-based meat is grown in a lab using cellular agriculture. Cellular agriculture is based on tissue engineering, which is best known for medical uses (called regenerative medicine) including bone, cartilage, heart, pancreas, vascular and cancer.
Intro to Cellular Agriculture
Tissue engineering requires a group of stem cells that are replicated and grown in a lab. These stem cells are taken from the biopsy of a living animal (so the process still requires animals). All cells – grown inside an animal or outside it – have requirements in order to grow correctly. Muscle cells require nutrients, oxygen, energy, waste removal, and cell adhesion, as well as the chemical, biological, and mechanical signals to grow. In a living animal, the circulatory system provides for most of these requirements. Also, they are connected to many other cells to communicate and work with to find food or a mate, avoid predators, etc. In a lab, this means growth media and scaffolding.

cellular agriculture Media
Since the technology is still developing, the media used to grow the cells is a bit of a mystery. Most contain serum – blood without blood cells – usually from cows or horses. Serum contains vital amino acids, fatty acids, vitamins, growth factors, hormones, and more to support growing cells. There have been studies on creating serum-free media, though they are not to the point they can economically remove animals from this part of the process.
In addition, muscle cells and fat cells are grown separately, not in a matrix-like they are in an animal. In order to create a hamburger, the stem cells from the biopsy of cow muscle are separated into muscle stem cells and fat stem cells to grow independently of one another. Some researchers are using this as an opportunity to encourage these fat cells to produce more omega-3 fatty acids, adjusting the omega-3:omega-6 ratio. Once they grow and develop, they are combined to create a meat-like product. It should also be noted that vitamin B12 and heme iron, two essential nutrients found in meat, do not come directly from muscle tissue: heme iron is found in blood and vitamin B12 is a byproduct of bacteria in the gut of the animal. Both of these nutrients would need to be added to the final product.
Scaffolding
A moment of honesty – tissue engineering scaffolding is not something I fully understand or feel comfortable explaining. To describe this part, I will rely on the words of experts:
“(S)uccessful scaffolding for 3D skeletal muscle formation is currently animal-derived due to… cell adhesion, fibre alignment and comparability to an in-vivo environment… To date, the only successful muscle tissue constructs have been a few hundred microns in thickness, which is acceptable for minced but not whole muscle cuts. Cell sheets are being explored for thicker tissue construction, however, for highly structured and organized tissues the engineering of highly perfused scaffolds would be required… Cells, not surprisingly, grow best on material found in the body such as collagen, which is common used in cell culture systems as a substrate… It is possible, but somewhat more difficult to grow cells under serum-free conditions or using serum replacements; however, this is itself an area of research that is yet to produce a comparable and affordable alternative.”
In summary: even with animal-derived scaffolding, scientists are a long way from producing a thick rib-eye or a pork chop. However, Aleph Farms has produced small, thin slices of meat.
Other considerations
In a hamburger, quality and texture can easily be altered by adding or removing fat. However, whole cuts of muscle are different. There is a reason a filet mignon has a different taste, texture, and mouthfeel than a rib-eye. Muscle:fat ratio differences play a part along with where the muscle is grown. The muscle grows differently based on where it grows on the animal and how often the animal uses it. This influences connective tissue, fat content, muscle type, and other factors that impact the quality of the meat. Perhaps these parameters can be adjusted in cellular agriculture, but it is not a topic I have seen discussed.
I hope this gives you a better idea of where this food comes from and how it is produced. In the next part of this blog series, I will explore potential environmental impacts and if cell-based meat can meet supporters’ expectations.
All posts are the opinion of the author and do not necessarily represent the view of the Animal Ag Alliance.